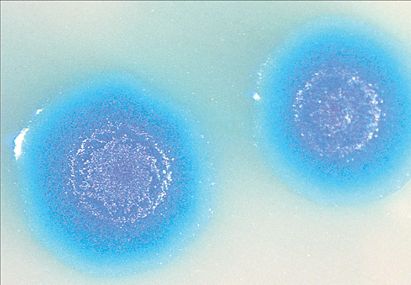

ΟΥΑΣΙΓΚΤΟΝ Το είπε και το έκανε. Ο Κρεγκ Βέντερ, ο αμφιλεγόμενος επιστήμονας που είχε συμμετάσχει ενεργά στην αποκωδικοποίηση του ανθρωπίνου γονιδιώματος, ανέφερε με κάθε ευκαιρία τα τελευταία χρόνια ότι θα δημιουργήσει ζωή από το μηδέν στο εργαστήριο. Πολλοί τον κατηγόρησαν ότι προσπαθεί να παραστήσει τον Θεό, άλλοι έλεγαν ότι δεν θα τα καταφέρει. Οποιες και αν ήταν οι αντιδράσεις, το γεγονός είναι πλέον ένα: ο Βέντερ και οι συνεργάτες του κατάφεραν, όπως ανακοίνωσαν χθες με δημοσίευσή τους στην έγκριτη επιθεώρηση «Science», να δώσουν «γέννηση» εντός του εργαστηρίου στο πρώτο τεχνητό κύτταρο. Οπως χαρακτηριστικά ανέφερε ο δρ Βέντερ κατά τη διάρκεια συνέντευξης Τύπου που παραχώρησε για να παρουσιάσει το επίτευγμά του, «δημιουργήσαμε το πρώτο είδος στον πλανήτη που μπορεί να πολλαπλασιάζεται και το οποίο έχει για γονέα έναν… υπολογιστή».
Οι ερευνητές από το Ινστιτούτο J. Craig Venter στο Μέριλαντ και στην Καλιφόρνια ουσιαστικώς δημιούργησαν ολόκληρο το «γενετικό λογισμικό» ενός βακτηρίου και το μεταμόσχευσαν σε ένα άλλο βακτήριο. Τι προέκυψε από αυτή τη μεταμόσχευση; Ζωή από το… τίποτε. Το μικρόβιο στο οποίο μεταμοσχεύθηκε το «γενετικό λογισμικό» εργαστηρίου έμοιαζε τόσο στη μορφή όσο και στη συμπεριφορά με το είδος στο οποίο ανήκε το συνθετικό DΝΑ. Η ομάδα από το Ινστιτούτο Venter είχε δημιουργήσει στο παρελθόν τεχνητό βακτηριακό γονιδίωμα. Παράλληλα είχε επιχειρήσει σε ξεχωριστό πείραμα μεταμόσχευση γονιδιώματος ενός βακτηρίου σε ένα άλλο. Τώρα οι επιστήμονες ένωσαν αυτές τις δύο μεθόδους για τη δημιουργία του τεχνητού κυττάρου (στην πραγματικότητα όμως μόνο το γονιδίωμά του είναι φτιαγμένο στο εργαστήριο).
Ο νέος οργανισμός που δημιουργήθηκε διαθέτει μια τεχνητή εκδοχή του DΝΑ ενός υπάρχοντος βακτηρίου- Μycoplasma mycoidesτο οποίο προκαλεί μαστίτιδα στις αίγες. Το τεχνητό γονιδίωμα που προέκυψε εισήχθη σε ένα άλλο βακτήριο-λήπτη, του είδους Μycoplasma capricolum, από το οποίο προηγουμένως είχε αφαιρεθεί το γενετικό υλικό.
Πώς όμως οι επιστήμονες δημιούργησαν το «λογισμικό» του κυττάρου; Αρχικώς αντέγραψαν το υπάρχον βακτηριακό γονιδίωμα και κατέγραψαν την αλληλουχία του γενετικού κώδικά του. Στη συνέχεια με ειδικά μηχανήματα χημικής σύνθεσης δημιούργησαν ένα αντίγραφο του κώδικα ο οποίος αποτελούνταν από περίπου 1 εκατομμύριο ζεύγη βάσεων. Ο τεχνητός αυτός γενετικός κώδικας μεταμοσχεύθηκε σε ένα άλλο κύτταρο. Μόλις το νέο «λογισμικό» εισήλθε εντός του κυττάρου-λήπτη, το κύτταρο «διάβασε» το λογισμικό και μετετράπη στο είδος που ορίζει ο γενετικός κώδικας. Ο οργανισμός που προέκυψε πολλαπλασιάστηκε μάλιστα περισσότερες από 1 δισεκατομμύριο φορές, παράγοντας αντίγραφα που έφεραν το τεχνητό DΝΑ. «Είναι η πρώτη φορά που βλέπουμε τεχνητό DΝΑ να βρίσκεται υπό τον πλήρη έλεγχο ενός κυττάρου» σημείωσε ο δρ Βέντερ στο ΒΒC και προσέθεσε ότι τα νέα βακτήρια… εργαστηρίου θα σημάνουν μια καινούργια βιομηχανική επανάσταση. Και μπορεί ο Βέντερ να μιλάει για ένα σημαντικό άλμα για το καλό της ανθρωπότητας, δεν είναι όμως λίγοι εκείνοι που έχουν ακριβώς αντίθετη άποψη, κατηγορώντας τον ότι δεν διστάζει να θυσιάσει τα πάντα στον βωμό της εμπορευματοποίησης. Η δρ Χέλεν Γουάλας από τον οργανισμό Genewatch UΚ, ο οποίος παρακολουθεί τις εξελίξεις στον τομέα των γενετικών τεχνολογιών, τόνισε ότι η χρήση συνθετικών βακτηρίων μπορεί να αποβεί άκρως επικίνδυνη. «Αν εκλυθούν τέτοιου είδους νέοι οργανισμοί στο περιβάλλον, είναι πιθανό να κάνουν περισσότερο κακό παρά καλό» είπε και συμπλήρωσε: «Για παράδειγμα, η έκλυση τέτοιων βακτηρίων σε περιοχές με ρύπανση θα δημιουργήσει ένα νέο είδος ρύπανσης».
Απαντώντας στις κατηγορίες ο Βέντερ σημείωσε ότι ο ίδιος με τις έρευνές του προκαλεί τις συζητήσεις σχετικά με το ρυθμιστικό πλαίσιο που θα ορίζει το νέο επιστημονικό πεδίο. Οπως χαρακτηριστικά ανέφερε, «το 2003, όταν δημιουργήσαμε τον πρώτο συνθετικό ιό, το επίτευγμα πέρασε από εξονυχιστική ανάλυση σε θέματα ηθικής η οποία έφθασε ως τον Λευκό Οίκο». Το ίδιο μπορεί να συμβεί και τώρα.
Εγκώμια και ανησυχίες
Το επίτευγμα του Βέντερ, για την πραγματοποίηση του οποίου απασχολήθηκαν 20 επιστήμονες για περισσότερα από 10 χρόνια και δαπανήθηκαν περί τα 40 εκατ. δολάρια, χαρακτηρίστηκε από κάποιους ορόσημο, μια «καθοριστική στιγμή της Βιολογίας», ένα σημαντικό βήμα προς τη δημιουργία πιο σύνθετων τεχνητών οργανισμών, οι οποίοι κάποια ημέρα θα παράγουν νέα καύσιμα, θα απορροφούν τα αέρια του θερμοκηπίου και θα επιταχύνουν την παραγωγή εμβολίων.
Αλλοι πάλι σχολίασαν ότι αυτό που κατάφεραν ο Βέντερ και η ομάδα του αποτελεί απλώς μια αναπαραγωγή υπάρχουσας ζωής, η οποία αφορά τη μετατροπή ενός απλού είδους βακτηρίου σε άλλο. Από την πλευρά τους ορισμένοι ειδικοί του τομέα της γενετικής αλλά και εκπρόσωποι θρησκευτικών ομάδων καταδίκασαν αυτού του είδους την έρευνα προειδοποιώντας ότι αν τεχνητοί οργανισμοί «δραπετεύσουν» στη φύση θα μπορούσαν να προκαλέσουν ένα περιβαλλοντικό χάος ή να μετατραπούν σε βιολογικά όπλα. Και βέβαια αρκετοί επανέλαβαν ότι ο Βέντερ θέλει να πάρει τη θέση του Υψίστου… Ο ίδιος ο Βέντερ πάντως υπεραμυνόμενος της προσπάθειάς του ανέφερε ότι το επίτευγμά του μπορεί να μην είναι του… Υψίστου αλλά είναι υψίστης σημασίας, αφού τον φέρνει πιο κοντά στον απώτερο στόχο: στον σχεδιασμό πιο σύνθετων οργανισμών που θα λειτουργούν με την παρέμβαση του ανθρώπου διαφορετικά από ό,τι είχε υπολογίσει η φύση…
Ποιος είναι ο «αμφιλεγόμενος» Κρεγκ Βέντερ
Επιτομή αυτού που θεωρείται «αμφιλεγόμενος επιστήμονας», ο Κρεγκ Βέντερ έχει εντυπωσιακή προϊστορία στο να ταράζει τα νερά και να εγείρει βαθείς προβληματισμούς γύρω από ζητήματα ηθικής και δεοντολογίας με τις επιλογές του. Ο αμερικανός βιολόγος έκανε την πρώτη σημαντική ανακάλυψή του προς τα τέλη της δεκαετίας του 1980, όταν εργαζόταν στο αμερικανικό Εθνικό Ινστιτούτο Υγείας, ταυτοποιώντας τμήματα αλληλουχιών του DΝΑ. Αυτή οδήγησε στην πρώτη μεγάλη διαμάχη του με τον υπόλοιπο επιστημονικό κόσμο όταν, πρωτοστατούντος του Ινστιτούτου, ενεπλάκη σε μια απόπειρα κατοχύρωσης εμπορικών δικαιωμάτων για αυτές τις αλληλουχίες. Το 1992 εγκατέλειψε το Ινστιτούτο και ίδρυσε τη Celera Genomics ανακοινώνοντας ότι θα αποκωδικοποιούσε το ανθρώπινο γονιδίωμα πολύ πιο γρήγορα και με πολύ μικρότερο κόστος από αυτό του δημόσιου Προγράμματος για το Ανθρώπινο Γονιδίωμα, το οποίο κατά τη γνώμη του κωλυσιεργούσε αδικαιολόγητα.
Τελικά, ύστερα από έντονο παρασκήνιο και κατηγορίες που δέχθηκε ότι έβαλε τους γενετιστές σε έναν αναίτιο αγώνα δρόμου, ο βιολόγος αναγκάστηκε να μοιραστεί τις δάφνες με τους συναδέλφους του τού «δημοσίου» σε μια κοινή παρουσίαση του πρώτου χάρτη του ανθρωπίνου γονιδιώματος στον Λευκό Οίκο το καλοκαίρι του 2000.
Το 2005 ίδρυσε τη Synthetic Genomics και αμέσως μετά το Ινστιτούτο J. Craig Venter, του οποίου είναι πρόεδρος. Οι- ομολογουμένως πολλοί- πολέμιοί του τον θεωρούν οπορτουνιστή, εγωκεντρικό και επιδειξιμανή ενώ του έχουν χαρίσει το προσωνύμιο «Νταρθ Βέιντερ» από τον ήρωα του «Πολέμου των Αστρων». Ο ίδιος τα αποδίδει όλα στον φθόνο: «Είμαι αγκάθι στο πλευρό τους εδώ και πολύ καιρό» έχει δηλώσει, «γιατί εγώ κάνω συνέχεια τις μεγάλες ανακαλύψεις. Δεν μπορούν να αποδεχθούν το γεγονός ότι έχουν ανταγωνιστή».